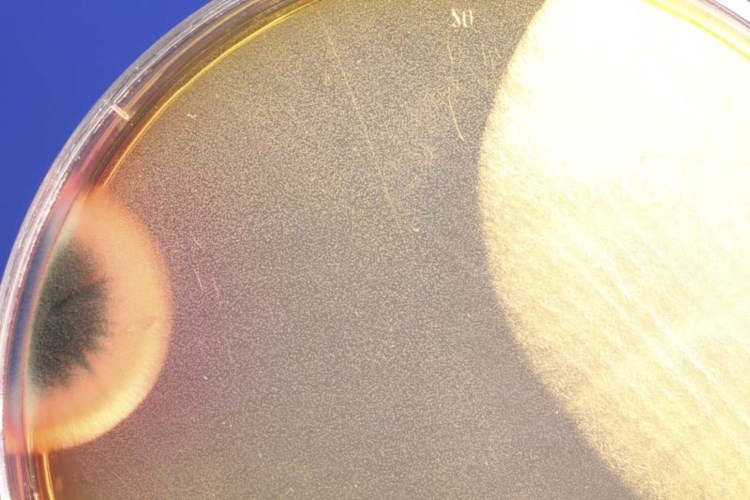
68328c61c3fae

Christine S.
30. March 2026
Super zuverlässig, ordentliche Ausführung, sehr kompetent. Preislich angemessen. Das ist mal ein Maler, der alles abdeckt, Bauteile schützt und seinen Müll am Schluss auch wieder mitnimmt. Perfekt!

Christine S.
30. March 2026
Super zuverlässig, ordentliche Ausführung, sehr kompetent. Preislich angemessen. Das ist mal ein Maler, der alles abdeckt, Bauteile schützt und seinen Müll am Schluss auch wieder mitnimmt. Perfekt!
Anja Leitner
30. March 2026
Die Sachverständigen Wittmann sind echt super, diese Erfahrung mit dieser Firma war echt Top. Hatte vorher schon einen Gutachter beauftragt, dieser hat im Vergleich nichts gemacht, ausser schnell Geld verdient. Jetzt fühlte ich mich super und vollständig beraten. Sollte ich nochmal Sachverständige brauchen, werde ich mich wieder an Firma Wittmann wenden.
Dirk Endter
30. March 2026
Sehr freundlich, zuverlässig und termintreu. Spürhunde ebenfalls sehr zuverlässig und finden die Ursache sehr schnell.
bianca kopp
30. March 2026
Super nettes Team schnelle Terminvergabe Sehr menschlich bei der Begutachtung sehr gut alles erklärt worden Kann ich nur weiter empfehlen
Dome GM
30. March 2026
Besser geht's nicht, super tolle Menschen und top ausgebildete Hunde.